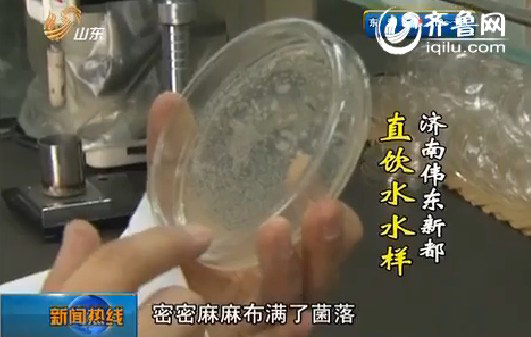
点击浏览下一页

水样检测结果触目惊心 菌落总数严重超标(视频截图)
齐鲁网12月3日讯 山东广播电视台新闻中心《早安山东》报道,水是生命之源,现在人们越来越多注意水的品质。除了桶装的纯净水,矿泉水,现在很多小区里都有自动售水机,出售所谓的直饮水,并宣传“现制现售、纯净、便宜”!不过济南有一位市民对此产生了怀疑,他们小区里就有一台自动售水机,说是生产直饮水,是看着那台自动售水机的样子,怎么看也不让人放心。
自动售水机锈迹斑斑 卫生状况堪忧
济南市天桥区西苑小区一位居民告诉记者,这台自动售水机是两年前有人安在小区里的,现在外表已经很破旧了,防护罩也没了,接水口就直接暴露在外边。“里面什么九层过滤什么的,从来没见他(维护人员)换过。光来擦擦就拉倒了,水应该是无色无味的东西,但是它发涩。”
而在济南伟东新都小区,也有两台类似的自动售水机,一台注明是直饮水,看起来比较新,一台注明是活性水,机器的外面已经出现了锈斑。“我看着时间挺长来保养一次,你直接喝吗,全都得烧开了,对多少层过滤还是不放心。”
记者了解到,目前济南市各大小区的自动售水机已经超过了3000台,价格每升在两毛钱左右,高出自来水六七倍。
水样检测结果触目惊心 菌落总数严重超标
从自动售水机里生产出来的水,能达到饮用水标准吗?带着疑问,记者在济南西苑小区和伟东新都小区的三台自动售水机里分别采集了水样,并送到专业的水质检验机构,五天后,检验结果出来了。
工作人员对我们送检的水样,分别进行了PH值、电导率、菌落总数和大肠菌群检测,没想到,检测结果让人大吃一惊。质检工作人员:“我们可以看这个比较细小的,一个小点,一个小点的,就是这个菌落,至少一百个。”
取自西苑小区的自动售水机,情况同样不容乐观,培养皿上出现了两个大的斑点。最令人触目惊心的,是从伟东新都小区的直饮水机中采集的三号送检水样。“我们直接用肉眼就能看得非常清楚,密密麻麻布满了菌落,应该至少在十万个以上。”
除此之外,在这份直饮水水样中,我们还看到了明显地絮状物。“我们轻轻地摇晃,会发现里面有很多的浑浊的物质产生,而且我们里面这个小导管,有气泡的产生,我们这个叫做产酸产气。”“证明这个试管里面有大肠杆菌的存在,所以说这个水是被大肠杆菌污染过的 我们不建议直接饮用的”。
目前,“直饮水”没有相应的国家检测标准,参照2007年发布的《生活饮用水卫生标准》,菌落总数应该每毫升小于等于100,总大肠菌群不得检出。而在记者送检的三种采样水中,不仅菌落总数全都超标,甚至还有大肠菌群的存在。
加盟门槛低 谁来监管
自动售水机进入济南市场已经有5年多时间,各大品牌售水机公司都声称“每年都有相关部门定期抽检水样,绝对符合直饮水标准”。可看到上面的检测结果,让人不免会质疑这一的说法。那么,这些自动售水机是怎么安到自家门口的?有没人对其水质安全进行监管呢?记者进行了调查采访。
“对于直饮水,目前没有参照的国家标准和行业标准,在使用过程中,水质的变化情况,没有人去监管。”这位业内人士告诉记者,自动售水机生产出来的水,不光无法保证水质合格,而且生产过程中,还严重浪费水。“一般是以自来水作为水源,出水率只有三分之一或者是四分之一 ,其他的直接排入下水道。”
记者又回到了之前采取水样的居民小区,在两台售水机旁,发现了排水口,直接就通向了下水道。部分售水机生产的水水质不合格,而且还都很浪费水,那自动售水机是怎么进入小区的呢?记者以加盟为由,联系了这家被检出水质污染最严重的售水机公司。
代理商称“一台售水机一万五千多元”, 带着所有的山东省疾控中心的检测检疫标志。然而对这一说法,山东省疾控中心给予了否定。“这个应该是属于执法部门管理的”
没有权威部门进行检测,售水机所有人只需联系小区物业就可以在小区内安装,那在安装之后谁来对售水机进行维护呢?“你购买一个水质检测仪器。超过标值就可以更换滤芯,不超过就继续用。”
业内人士称,售水机水质是否达标,很大程度上取决于滤芯能否定期更换。那么,这种自动售水机到底该由谁来监管,记者先后联系了疾控、工商、卫生、质监等部门,最终,找到了济南市卫生局卫生监督所。工作人员称会有专业人员去检测,如果检测的结果不合格会让自动售水机商家改正,然而济南市卫生局卫生监督所并没有相关处罚权。
编后:自动售水机,成本小、利润大,有市场。可为何这种机器进入济南5年多了,至今缺乏监管、检测、处罚机制呢?希望有关部门能明确责任,加强监管,让这种号称可以直饮的净水设备,能真正做到安全、卫生、直饮。